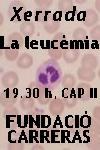
.

Xerrada sobre la leucèmia
- https://www.ripollet.cat/actualitat/agenda/2805
- Xerrada sobre la leucèmia
- 2004-01-23T19:30:00+01:00
- 2004-01-23T00:00:00+01:00
- Quan? 23/01/2004 de 19:30 a 00:00
-
Afegiu l'esdeveniment al calendari
iCal
- On? CAP II - CUAP (Urgències)
A càrrec de la Fundació Carreras